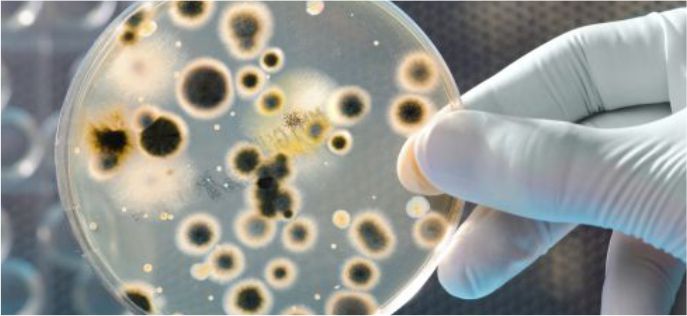

Our foundation is built on maintaining high standards of excellence in printing, utilizing in-house facilities to provide color printing services for various items.
Lumis Enzymes manufactures unique single enzymes designed to optimize animal nutrition. With exceptional features, our enzymes deliver outstanding, consistent, and reliable results across a variety of feeding environments.
Lumis, through its extensive research and development has developed a very distinctive xylanase. Lumis is not only the market leader to offer such an innovative and valuable xylanase to the feed industry but has also set a new bench mark for other enzyme producers.
Lumis offers a highly heat stable Beta-Mannanase which helps to improve growth performance by efficiently breaking mannans in diets such as Soya, Guar, Palm, Copra, DDGS, etc. It enhances the performance of disease challenged broilers and improves egg weight and production in layers. It also increases the insulin secretion and improves energy metabolism in swine leading to uniformity in the animal body weight.
Beta Glucanase offered by Lumis helps in digesting and breaking down the beta-glucans and complex carbohydrates in the plant cell walls especially in high fibre ingredients such as barley and other grains like wheat, rye, triticale etc. leading to increased energy release from the feed ingredients.
Cellulase offered by Lumis, degrades cellulose fibers thereby reducing water holding capacity leading to improved feed intake and animal growth. Cellulose fibers in cereals and legumes can be digested properly making it available as energy.
Pectinase offered by Lumis gives the best result in diets containing legumes like soya, beans and peas. The usage of Pectinase in feed production reduces the feed viscosity increasing nutrient release and absorption either by hydrolysis of non-biodegradable fibres or by liberating nutrients blocked by these fibres.
Galactosidase offered by Lumis helps in removing flatulence (gas) producing compounds in diets such as soyabean thereby improving the nutrient digestibility and growth performance.
Lumis, through its pioneering launch of triple acting proteases has been explempary in creating a quintessential protease for the feed industry. The multi-protease combination is uniquely designed and has an array of exceptional features over any single proteases in the industry. Lumis multi-protease has received widespread success across the globe, due to its efficiency on a broad range of conventional and alternate protein ingredients.
Lumis Biotech offers a novel blend of multiple Amylases that works at wide pH condition and is highly thermo-stable. It increases starch digestibility of plant based raw materials releasing glucose which can be easily absorbed by the animals digestive system. It provides more available energy and essential nutrients while improving the animal performance. It is effective against different starches and starches with higher amylose contents. It thus helps in providing flexibility in using cost effective starch based raw materials.
Lumis Lipase breaks down fats in majority of feed ingredients thereby improving animal digestion and subsequent utilization of fat. Lipase is useful in all oil based raw materials like vegetable oil, tallow, animal based oil etc.
Lumis phytase is a new generation phytase that has some outstanding features complementing the requirements of the current feed industry. Our phytase is positioned well amongst the major phytase manufacturers globally.
For further inquiries please contact: info@feedenzymes.com or info@lumisbiotech.com